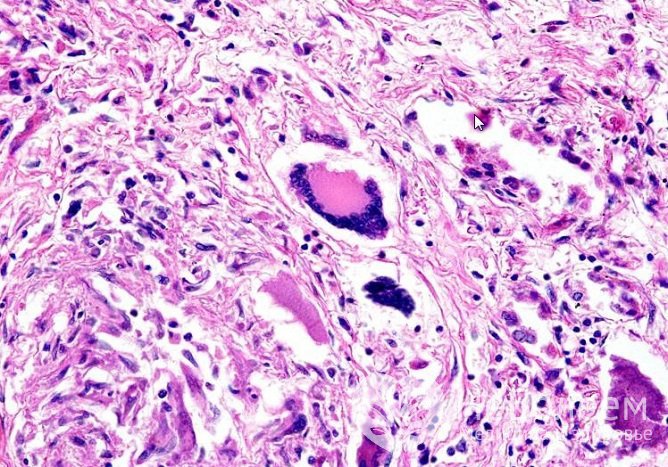
Гранулематоз Вегенера – аутоиммунное гранулематозное воспаление стенок сосудов (васкулит)

Воспользуйтесь поиском по сайту:
Гранулематоз Вегенера
Содержание статьи:
Гранулематоз Вегенера – системный гранулематозно-некротический гигантоклеточный васкулит, который первоначально поражает верхние и нижние дыхательные пути, а в дальнейшем – почки.
Достоверных статистических данных о заболеваемости гранулематозом Вегенера и его распространенности нет. Болезнь чаще наблюдается у мужчин молодого и среднего возраста, практически не встречается в детском возрасте.
Гранулематоз Вегенера – аутоиммунное гранулематозное воспаление стенок сосудов (васкулит)
Гранулематоз Вегенера – аутоиммунное гранулематозное воспаление стенок сосудов (васкулит)Причины и факторы риска
Точные причины возникновения гранулематоза Вегенера неизвестны. Учитывая, что в крови при рассматриваемом заболевании обнаруживаются иммунные комплексы, его относят к аутоиммунным патологиям. Предположительно, болезнь развивается в результате ошибки иммунной системы, вследствие которой ткани сосудистых стенок воспринимаются иммунной системой как чужеродные и подлежат разрушению. К этому могут привести различные воспалительные процессы, в том числе инфекционные.
 При гранулематозе Вегенера иммунные клетки атакуют стенки сосудов и окружающую ткань
При гранулематозе Вегенера иммунные клетки атакуют стенки сосудов и окружающую тканьИммунная система, определяя собственную ткань как чужеродную, вырабатывает к ней антитела. Антитела повреждают стенки кровеносных сосудов, что влечет образование участков воспаления, то есть гранулем. Постепенно увеличиваясь в размере, гранулемы закрывают просвет сосуда. В итоге нарушаются кровоснабжение тканей, процессы тканевого дыхания и метаболизма.
Формы заболевания
В зависимости от степени распространения патологических изменений выделяют две формы гранулематоза Вегенера:
- локализованную. Поражается преимущественно верхний отдел дыхательной системы, что проявляется осиплостью голоса, частыми носовыми кровотечениями, образованием в полости носа кровянистых корочек, упорным ринитом;
- генерализованную. Характерны обширные системные проявления (лихорадка, абсцедирующие пневмонии, суставно-мышечные боли, нарастание признаков почечной, сердечно-сосудистой и дыхательной недостаточности).
Прогноз при гранулематозе Вегенера при отсутствии адекватного и своевременного лечения крайне неблагоприятный. Более 90% больных погибают в первые два года от момента постановки диагноза.
Стадии заболевания
В клинической картине гранулематоза Вегенера выделяют несколько стадий:
- Риногенный гранулематоз (гранулематозно-некротический васкулит). Развиваются язвенно-некротический или гнойно-некротический риносинусит, назофарингит, ларингит, деструктивные изменения глазницы и носовой перегородки.
- Легочный гранулематоз. Патологический процесс захватывает легочную ткань.
- Генерализованный гранулематоз. Поражаются нижние отделы дыхательной системы, сердечно-сосудистая система, органы пищеварительного тракта и почки.
- Терминальный гранулематоз. Развивается почечная и (или) легочная недостаточность. Летальный исход наступает в течение года от момента перехода заболевания в терминальную стадию.
Симптомы гранулематоза Вегенера
К общим симптомам гранулематоза Вегенера относятся:
- повышение температуры тела с ознобом;
- выраженная слабость;
- гипергидроз (повышенная потливость);
- боли в суставах и мышцах;
- потеря массы тела.
У 90% пациентов гранулематоз Вегенера проявляется поражением верхнего отдела дыхательной системы. Формируется хронический ринит, устойчивый к проводимой терапии, который сопровождается гнойно-кровянистым отделяемым. На слизистой оболочке носовой полости образуются язвенные дефекты. Постепенно увеличиваясь в размере, они приводят к перфорации носовой перегородки, седловидной деформации носа. Наличие гранулематозно-некротических изменений также выявляется в придаточных пазухах носа, наружных слуховых проходах, трахее, гортани и полости рта.
 Симптомы гранулематоза Вегенера
Симптомы гранулематоза ВегенераУ 2/3 пациентов заболевание сопровождается образованием в легких деструктивных полостей, упорным кашлем, кровохарканьем.
Вовлечение в патологический процесс сосудов почек приводит к развитию гломерулонефрита, а в дальнейшем – почечной недостаточности.
Кожные симптомы гранулематоза Вегенера заключаются в появлении геморрагической сыпи, элементы которой склонны к некротизации.
Могут также поражаться глаза, нервная система, миокард, коронарные артерии.
Читайте также:16 причин кровоизлияний в глазах
5 состояний, о которых сигнализирует повышенная потливость
Как сохранить здоровье почек: 10 привычек, от которых необходимо отказаться
Диагностика гранулематоза Вегенера
При подозрении на гранулематоз Вегенера проводят инструментально-лабораторное обследование:
- общий анализ крови (на тромбоцитоз, ускорение СОЭ, нормохромную анемию);
- общий анализ мочи (выявляются микрогематурия, протеинурия);
- биохимический анализ крови (на повышение гаптоглобина, серомукоида, фибрина, мочевины, креатинина, γ-глобулина);
- рентгенография легких (на плевральный экссудат, полости распада, инфильтраты);
- иммунодиагностика (устанавливаются снижение уровня комплемента, присутствие антинейтрофильных антител, антигенов класса HLA – B8, B7, DR2 и DQW7).
 Рентгенография легких – легочные узлы при гранулематозе Вегенера
Рентгенография легких – легочные узлы при гранулематозе ВегенераПри необходимости в диагностике гранулематоза Вегенера используют и другие методы: например, компьютерную томографию или биопсию тканей верхних дыхательных путей с последующим гистологическим анализом.
Гранулематоз Вегенера чаще наблюдается у мужчин молодого и среднего возраста, практически не встречается в детском возрасте.
Лечение гранулематоза Вегенера
Основной метод лечения гранулематоза Вегенера – иммуносупрессивная терапия, которая проводится комбинацией циклофосфамида и преднизолона. По мере улучшения состояния пациента их дозировку постепенно снижают до полной отмены. После этого пациенту назначают метотрексат длительным курсом (1,5-2 года).
 При гранулематозе Вегенера показан Метотрексат длительным курсом до 2-х лет
При гранулематозе Вегенера показан Метотрексат длительным курсом до 2-х летВ терапии генерализованной формы гранулематоза Вегенера применяют методы экстракорпоральной гемокоррекции:
- экстракорпоральную фармакотерапию;
- каскадную фильтрацию плазмы;
- плазмаферез;
- криоаферез.
Возможные осложнения и последствия
Прогрессирующее течение гранулематоза Вегенера может осложняться:
- кровохарканьем;
- глухотой;
- деструкцией костей лицевого черепа;
- гангреной стоп;
- образованием участков некроза в паренхиме легких;
- вторичными инфекциями на фоне иммуносупрессивной терапии;
- почечной недостаточностью.
У 90% пациентов гранулематоз Вегенера проявляется поражением верхнего отдела дыхательной системы.
Прогноз при гранулематозе Вегенера
Прогноз при гранулематозе Вегенера при отсутствии адекватного и своевременного лечения крайне неблагоприятный. Более 90% больных погибают в первые два года от момента постановки диагноза.
На фоне иммуносупрессивной терапии у 85% больных отмечается значительное улучшение, у 75% больных заболевание переходит в стадию ремиссии. Более чем в половине случаев ремиссия длится около года, после чего наступает обострение.
У 13% пациентов болезнь оказывается устойчивой к проводимой иммуносупрессивной терапии и отличается постоянно прогрессирующим течением.
Профилактика
Ввиду того, что точная причина возникновения гранулематоза Вегенера неизвестна, меры по его профилактике не разработаны.
Об авторе

Опыт работы: врач анестезиолог-реаниматолог городского родильного комплекса, врач реаниматолог отделения гемодиализа.
Информация является обобщенной и предоставляется в ознакомительных целях. При первых признаках болезни обратитесь к врачу. Самолечение опасно для здоровья!
Самая высокая температура тела была зафиксирована у Уилли Джонса (США), который поступил в больницу с температурой 46,5°C.
























